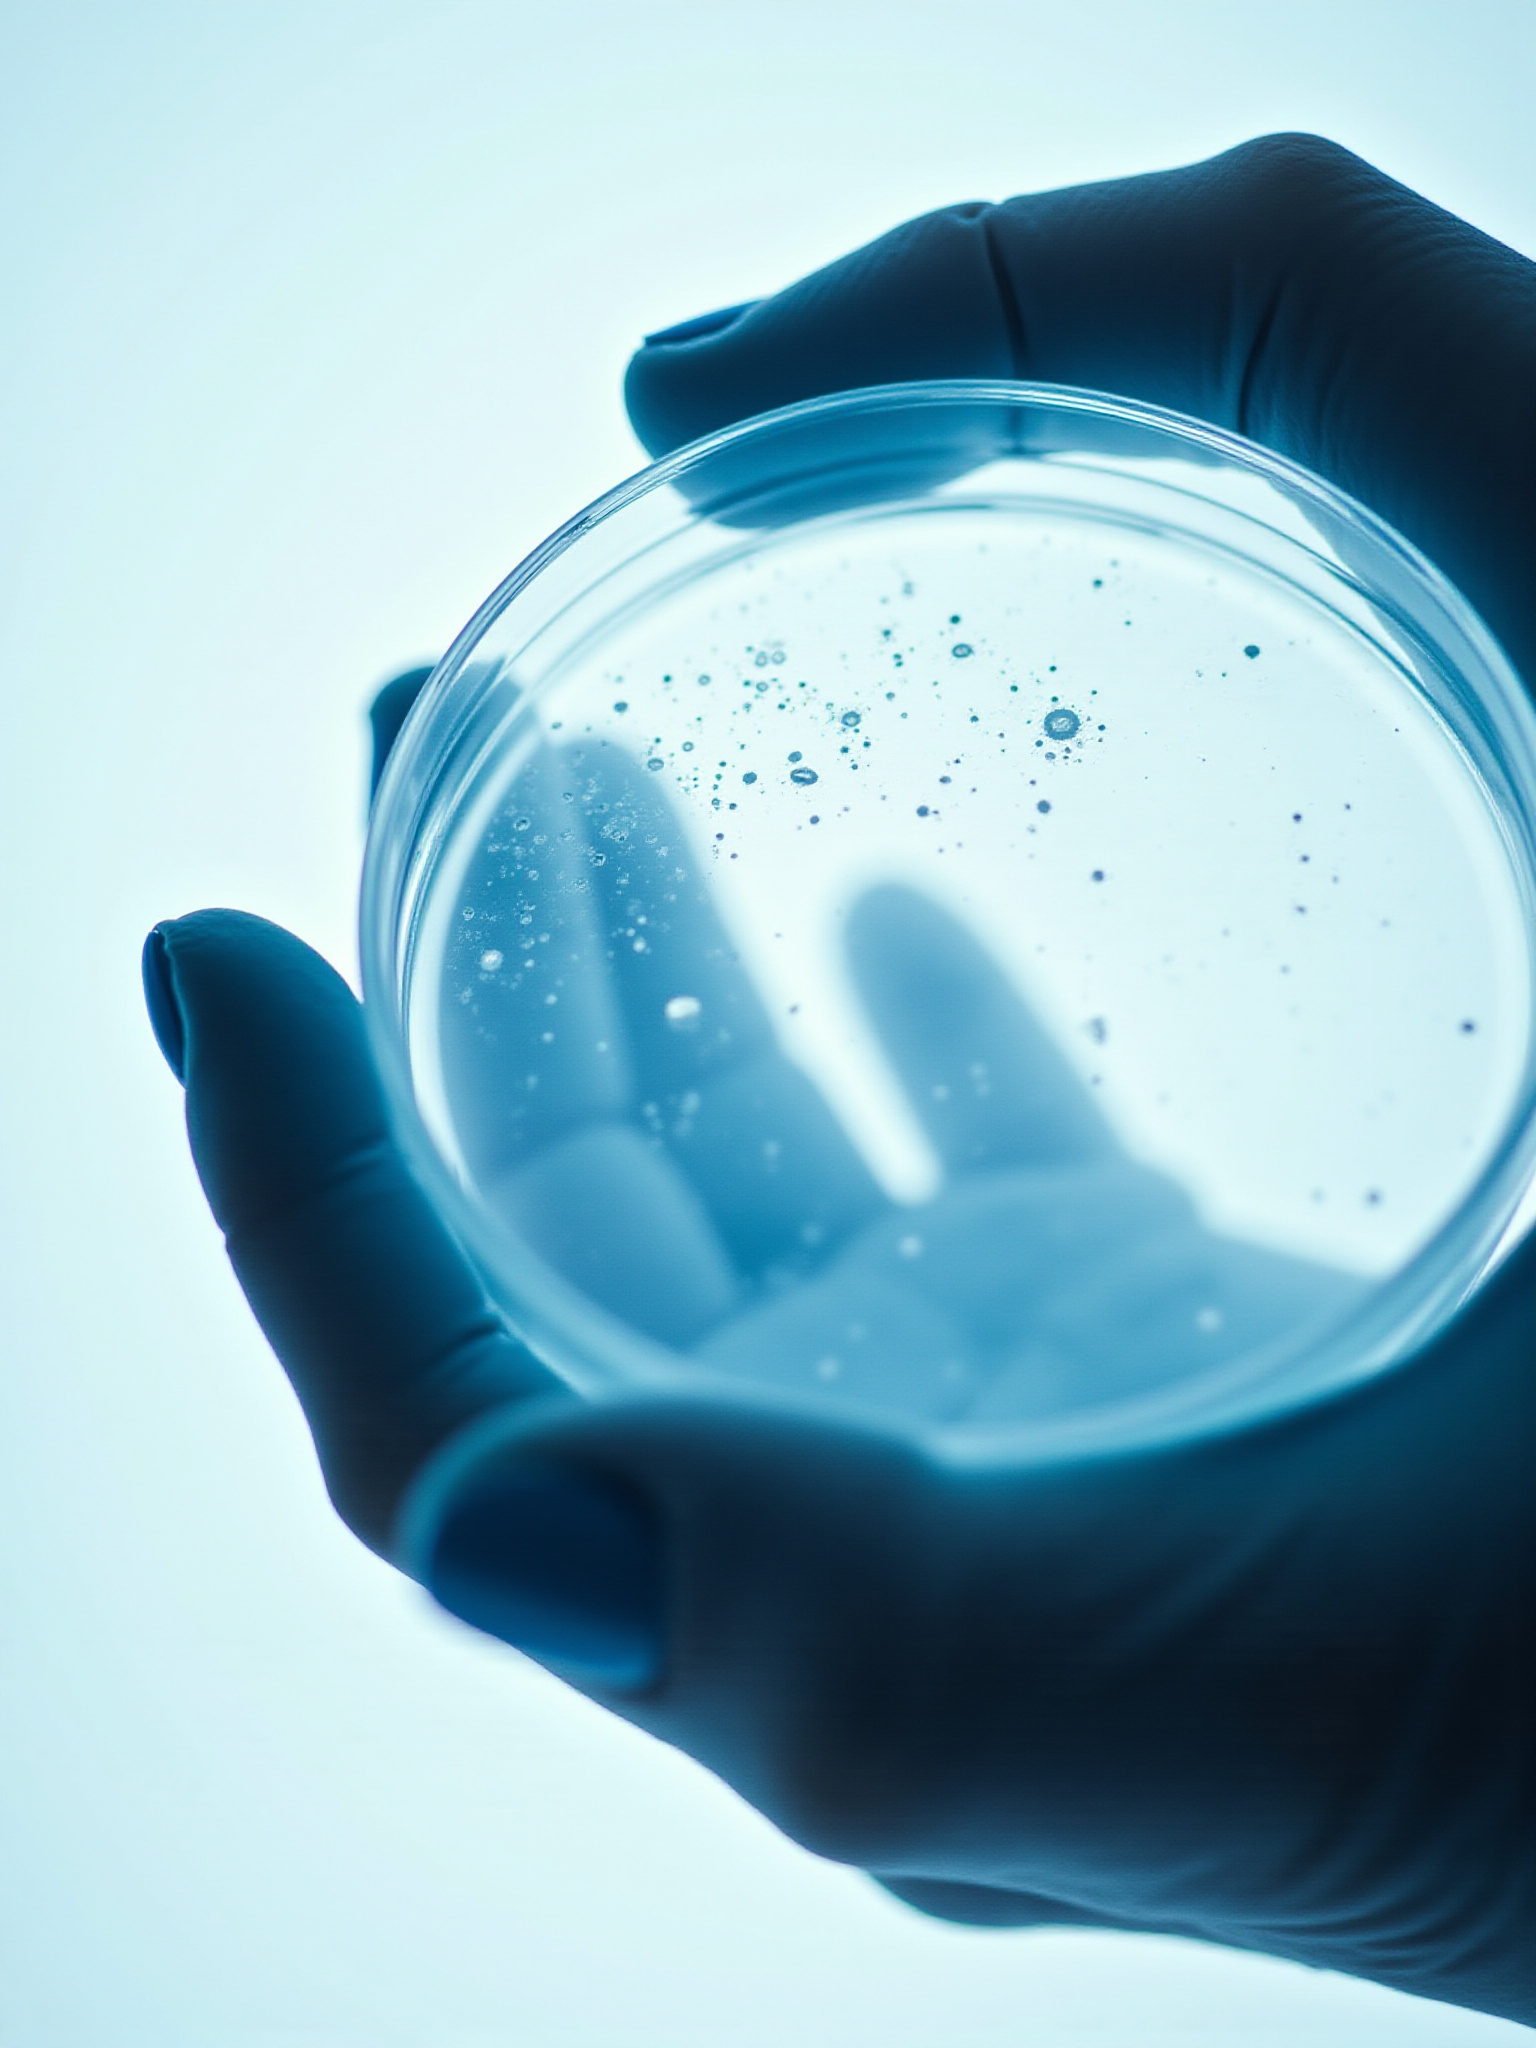

top of page

Bien plus q'une simple analyse d'air !
Notre entreprise se distingue par des explications claires, des délais rapides et une expertise de plus de 17 ans en décontamination. Nous sommes passionnés par le domaine de l'assainissement et du rétablissement du patrimoine. Faites confiance à notre équipe pour vous offrir un service professionnel et efficace, adapté à vos besoins.
Services
- 440 dollars canadiens
- 220 dollars canadiens
- 220 dollars canadiens
- 220 dollars canadiens
- 885 dollars canadiens
- 2 225 dollars canadiens
- 890 dollars canadiens
- 555 dollars canadiens
- 435 dollars canadiens
Qui Sommes-Nous
Analyse Air est une société de conseil spécialisée dans l'analyse de moisissures et d'amiante, ainsi que la caractérisation des matériaux pour une remédiation efficace. Nous offrons des services avec des conseils personnalisés pour assurer la santé de votre environnement intérieur. Notre objectif est d'améliorer la qualité de vie en vous offrant des solutions fiables et durables.
bottom of page
